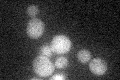
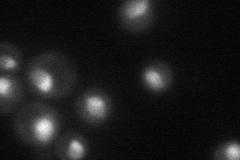
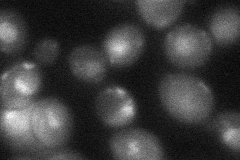
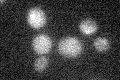

View description
GTPase required for synthesis of 40S ribosomal subunits and for processing the 35S pre-rRNA at sites A0, A1, and A2; interacts with Rcl1p, which stimulates its GTPase and U3 snoRNA binding activities; has similarity to Tsr1p
Localization:
Intensity:
Fold change:
Significance:
-
C’ GFP library in SD
below threshold19 -
N' NOP1pr-GFP in SD

nucleus100.279 -
N' TEF2pr-mCherry in SD
nucleus,nucleolus40.8913 -
N' NATIVEpr-GFP in SD

punctate17.3014 -
N' TEF2pr-VC and Cyto-VN in SD
nucleus35.9173 -
C’ GFP library in SD+DTT

cytosol18.080.95No -
C’ GFP library in SD+H2O2

cytosol21.181.11No -
C’ GFP library in Starvation Media
cytosol16.580.87No -
C’ GFP library on the background of Pup2-DaMP

below threshold -
C’ GFP library on the background of CCT mutant

below threshold20.41881.07445No
